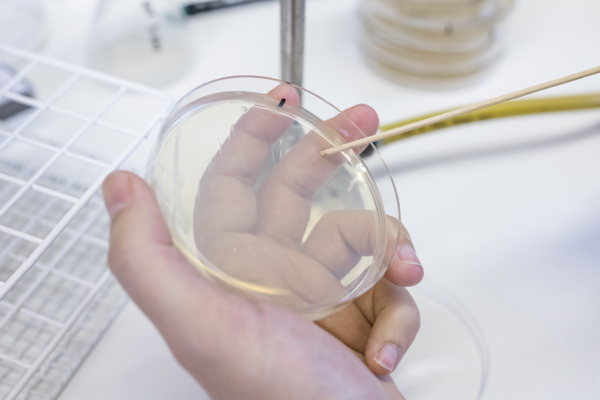
Bakteria

MIMS har tillkännagivit 2025 års mottagare av det nationella Clinical Research Fellowship (CRF)-programmet. En internationell expertpanel bestående av kliniska och prekliniska forskare har tilldelat stipendiet till Alicia Lind vid Norrlands universitetssjukhus i Umeå, för hennes forskningsprojekt som syftar till att förbättra diagnostik och behandlingsresultat vid postcovidsyndrom (PCC).
MIMS
The Laboratory for Molecular Infection Medicine Sweden
MIMS är den svenska partnern i Nordic EMBL Partnership for Molecular Medicine

Öppna utlysningar i rampljuset
MIMS Clinical Research Fellowships - Utlysning 2026
MIMS Clinical Research Fellowships ger kliniker i början av sin karriärmöjlighet att utveckla ett forskningsprojekt inom det breda området infektionsmedicin i samarbete med en grundforskare.
Ansökningsperioden avslutas: 16 januari 2026. Läs hela beskrivningen och ansök här.

2025 års MIMS Clinical Research Fellowship har officiellt tilldelats

Mjölkbaserad molekyl stärker tarmhälsan även vid ohälsosam kost
Forskare från MIMS gruppledare Björn Schröders laboratorium har, i samarbete med Arla Foods Ingredients, identifierat en mjölkbaserad molekyl som avsevärt kan stärka tarmslemhinnans funktion och bana väg för nya koststrategier.
Life science i Umeå: Where curiosity meets discovery
Oavsett om du är i början av din vetenskapliga karriär eller letar efter nästa steg i din karriär är Umeå i norra Sverige en idealisk plats för forskare och studenter från hela världen att utvecklas på. Titta på den här videon för att lära dig mer.
HOT OFF THE PRESS

Att läsa livets kod – datadriven livsvetenskap
Titta på den här videon för att följa forskarna inom DDLS-programmet i deras strävan efter ny kunskap.

Genombrott: Vägen för TBE-virusets inträde i kroppen upptäckt
Vetenskaplig artikel: LRP8 is a receptor for tick-borne encephalitis virus. Nature (2025)
Upptäckt vid Umeå universitet tilldelas Nobelpriset i kemi
Forskningsområden
Upptäck de olika forskningsområden som MIMS forskare är engagerade i

Våra berättelser
Läs de senaste artiklarna om vår forskning och våra forskare

Jobba hos oss
Ta reda på vilka lediga tjänster som finns










